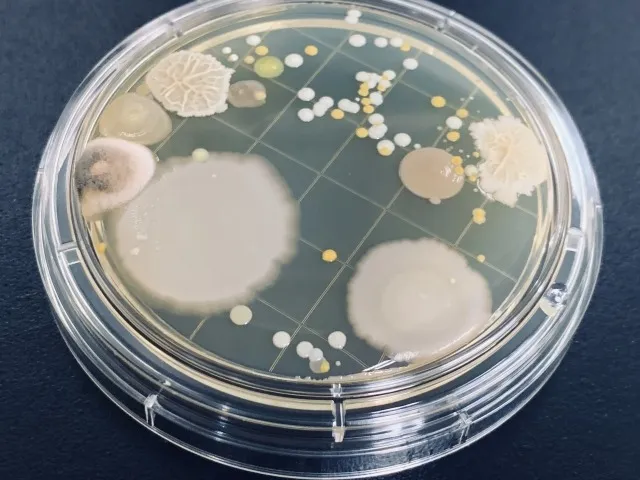

カビに関する情報を発信します
カビバスターズグループ
出演依頼受付中
カビバスターズでは、グループ独自のMIST工法®を用いて、戸建てやマンション・アパートなどの住宅から神社、国宝などといった歴史ある品物までのありとあらゆるカビ問題に対応してまいりました。これまで培った実績から各メディア出演・取材などを通してカビに関するご相談やお悩み、対処法などをお伝えします。カビに関することなら実績多数のカビバスターズ沖縄にお任せください。
カビに関する取材は
カビバスターズ沖縄まで
最新の出演情報
カビのご相談お伺いします
各種メディア取材・出演依頼受付中!
カビバスターズ沖縄では、各種メディア取材、出演依頼を受け付けております。どんなご依頼でも皆様のニーズに合わせて対応いたします。また、視聴者のすべての方が理解しやすい言葉でカビに関する情報をたくさん発信していきます。TV出演・取材・掲載などのご依頼はお問い合わせもしくは、お電話からお願いいたします。
TV取材協力(過去出演番組一覧)
TBSテレビ 番組名「あさチャン!」
読売テレビ 番組名「かんさい情報ネットTen.」
読売テレビ 番組名「す・またん!ZIP!」
テレビ愛知 番組名「ゆうがたサテライト」
東海テレビ放送 番組名「スイッチ!」
テレビ朝日 番組名「羽鳥慎一モーニングショー」
中京テレビ 番組名「キャッチ!」
山口朝日放送 番組名「YOU!どきっ」
テレビ東京 番組名「生活情報マーケット なないろ日和!」
テレビ東京 番組名「日曜ビッグバラエティ ニッポン激ヤバ地帯を大掃除!坂上忍のピカピカ団」
RKB毎日放送 番組名「タダイマ!」
フジテレビ 番組名「サン!シャイン!」
フジテレビ 番組名「めざましテレビ」
フジテレビ 番組名「ノンストップ!」
CBCテレビ 番組名「newsX」
CBCテレビ 番組名「ゴゴスマ」
CBCテレビ 番組名「チャント!」
CBCテレビ 番組名「イッポウ」
NHK 番組名「まるっと!」
※敬称略・順不同
カビ取りに関するあらゆるご相談
メディア対応内容
カビに関する
情報発信への取り組み
カビバスターズ沖縄では、これまでの豊富な施工実績と専門知識をもとに、カビに関する正確で分かりやすい情報発信を行っております。メディア出演や取材を通じて、視聴者や読者の方にとって役立つカビ対策や予防方法をお伝えし、社会全体のカビ問題の理解向上に貢献してまいります。カビに関する取材や専門家コメントが必要な際は、ぜひお気軽にご相談ください。